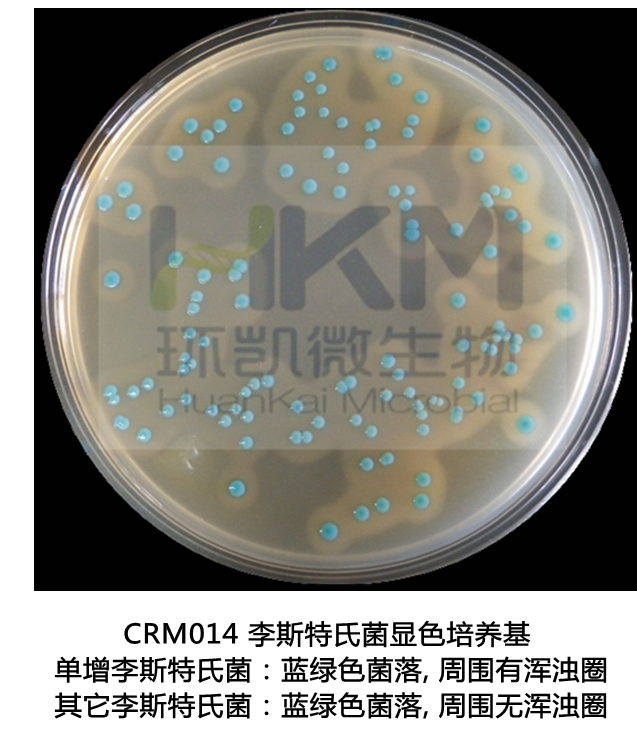

單核細(xì)胞增生李斯特氏菌是一種人畜共患病的病原菌。它能引起人畜的李氏菌的病,感染后主要表現(xiàn)為敗血癥、腦膜炎和單核細(xì)胞增多。它廣泛存在于自然界中,食品中存在的單增李氏菌對(duì)人類的安全具有危險(xiǎn),該菌在4℃的環(huán)境中仍可生長(zhǎng)繁殖,是冷藏食品威脅人類健康的主要病原菌之一,因此,在食品衛(wèi)生微生物檢驗(yàn)中,必須加以重視。
一、生物學(xué)特性
1、形態(tài)與染色
該菌為革蘭氏陽(yáng)性短桿菌,大小約為0.5μmх1.0-2.0μm,直或稍彎,兩端鈍圓,常呈V字型排列,偶有球狀、雙球狀,兼性厭氧、無(wú)芽胞,一般不形成莢膜,但在營(yíng)養(yǎng)豐富的環(huán)境中可形成莢膜,在陳舊培養(yǎng)中的菌體可呈絲狀及革蘭氏陰性,該菌有4根周毛和1根端毛,但周毛易脫落。
2、培養(yǎng)特性
該菌營(yíng)養(yǎng)要求不高,在20--25℃培養(yǎng)有動(dòng)力,穿刺培養(yǎng)2-5天可見倒立傘狀生長(zhǎng),肉湯培養(yǎng)物在顯微鏡下可見翻跟斗運(yùn)動(dòng)。該菌的生長(zhǎng)范圍為2--42℃(也有報(bào)道在0℃能緩慢生長(zhǎng)),最適培養(yǎng)溫度為35--37℃,在pH中性至弱堿性(pH9.6)、氧分壓略低、二氧化碳張力略高的條件下該菌生長(zhǎng)良好,在pH3.8 - PH4.4能緩慢生長(zhǎng),在6.5% NaCl 肉湯中生長(zhǎng)良好。在固體培養(yǎng)基上,菌落初始很小,透明,邊緣整齊,呈露滴狀,但隨著菌落的增大,變得不透明。在5-7%的血平板上,菌落通常也不大,灰白色,刺種血平板培養(yǎng)后可產(chǎn)生窄小的β-溶血環(huán)。在0.6%酵母浸膏胰酪大豆瓊脂(TSAYE)和改良Mc Bride(MMA)瓊脂上,用450角入射光照射菌落,通過解剖鏡垂直觀察,菌落呈蘭色、灰色或蘭灰色。
3、生化反應(yīng)
該菌觸酶陽(yáng)性,氧化酶陰性,能發(fā)酵多種糖類,產(chǎn)酸不產(chǎn)氣,如發(fā)酵葡萄糖、乳糖、水楊素、麥芽糖、鼠李糖、七葉苷、蔗糖(遲發(fā)酵)、山梨醇、海藻糖、果糖,不發(fā)酵木糖、甘露醇、肌醇、阿拉伯糖、側(cè)金盞花醇、棉子糖、衛(wèi)矛醇和纖維二糖,不利用枸櫞酸鹽,40%膽汁不溶解,吲哚、硫化氫、尿素、明膠液化、硝酸鹽還原、賴氨酸、鳥氨酸均陰性,VP、甲基紅試驗(yàn)和精氨酸水解陽(yáng)性。
二、檢驗(yàn)

1. 增菌培養(yǎng)
以無(wú)菌操作取樣品25g(mL)加入到含有225mL LB1 增菌液的均質(zhì)袋中,在拍擊式均質(zhì)器上連續(xù)均質(zhì)1min~2min;或放入盛有225mL LB1 增菌液的均質(zhì)杯中,以8000r/min~10000r/min均質(zhì)1min~2min。于30℃±1℃培養(yǎng)24h±2h,移取0.1mL,轉(zhuǎn)種于10mL LB2 增菌液內(nèi),于30 ℃±1℃ 培養(yǎng)24h±2h。
2. 分離
取LB2 二次增菌液劃線接種于李斯特氏菌顯色平板和PALCAM 瓊脂平板,于36 ℃±1 ℃培養(yǎng)24h~48h,觀察各個(gè)平板上生長(zhǎng)的菌落。典型菌落在PALCAM 瓊脂平板上為小的圓形灰綠色菌落,周圍有棕黑色水解圈,有些菌落有黑色凹陷(圖1);在李斯特氏菌顯色平板上的菌落特征(圖2),參照產(chǎn)品說明進(jìn)行判定。

圖1 PALCAM 瓊脂平板上的典型菌落 圖2 李斯特顯色培養(yǎng)基平板上典型菌落
3. 初篩
自選擇性瓊脂平板上分別挑取3個(gè)~5個(gè)典型或可疑菌落,分別接種木糖、鼠李糖發(fā)酵管,于36℃±1℃ 培養(yǎng)24h±2h,同時(shí)在TSA-YE平板上劃線,于36℃±1℃培養(yǎng)18h~24h,然后選擇木糖陰性、鼠李糖陽(yáng)性的純培養(yǎng)物繼續(xù)進(jìn)行鑒定。
4. 鑒定(或選擇生化鑒定試劑盒或全自動(dòng)微生物鑒定系統(tǒng)等)
4.1 染色鏡檢:
李斯特氏菌為革蘭氏陽(yáng)性短桿菌(圖3),大小為(0.4μm~0.5μm)×(0.5μm~2.0μm);用生理鹽水制成菌懸液,在油鏡或相差顯微鏡下觀察,該菌出現(xiàn)輕微旋轉(zhuǎn)或翻滾樣的運(yùn)動(dòng)。

圖四、革蘭氏陽(yáng)性短桿菌 圖五、動(dòng)力試驗(yàn):傘狀生長(zhǎng)
4.2 動(dòng)力試驗(yàn):
挑取純培養(yǎng)的單個(gè)可疑菌落穿刺半固體或SIM 動(dòng)力培養(yǎng)基,于25 ℃~30 ℃培養(yǎng)48h,李斯特氏菌有動(dòng)力,在半固體或SIM 培養(yǎng)基上方呈傘狀生長(zhǎng)(圖4),如傘狀生長(zhǎng)不明顯,可繼續(xù)培養(yǎng)5d,再觀察結(jié)果。
4.3 生化鑒定: 挑取純培養(yǎng)的單個(gè)可疑菌落,進(jìn)行過氧化氫酶試驗(yàn),過氧化氫酶陽(yáng)性反應(yīng)的菌落可選擇HK-MID李斯特氏菌生化鑒定系統(tǒng)進(jìn)行生化鑒定。


5. 小鼠毒力試驗(yàn)
將分離的菌株接種到10 mL TSBYE肉湯中,35℃培養(yǎng)24h,將培養(yǎng)物離心、濃縮,用1mL生理鹽水制成菌懸液(濃度為1010個(gè)菌/mL),取0.1mL腹腔注射體重為16-18g 小鼠,每組5個(gè)觀察7d內(nèi)小鼠死亡情況。用已知致病的單增李斯特氏菌和非致病的英諾克李斯特氏菌相同方法進(jìn)行,做對(duì)照試驗(yàn)。
三、控制
單增李斯特氏菌在一般熱加工處理中能存活,熱處理已殺滅了競(jìng)爭(zhēng)性細(xì)菌群,使單增李斯特氏菌在沒有競(jìng)爭(zhēng)的環(huán)境條件下易于存活,所以在食品加工中,中心溫度必須達(dá)到70℃持續(xù)2分鐘以上。
單增李斯特氏菌在自然界中廣泛存在,所以即使產(chǎn)品已經(jīng)過熱加工處理充分滅活了單增李斯特氏菌,但有可能造成產(chǎn)品的二次污染,因此蒸煮后防止二次污染是極為重要的。
由于單增李斯特氏菌在4℃下仍然能生長(zhǎng)繁殖,所以未加熱的冰箱食品增加了食物中毒的危險(xiǎn)。冰箱食品需加熱后再食用。
